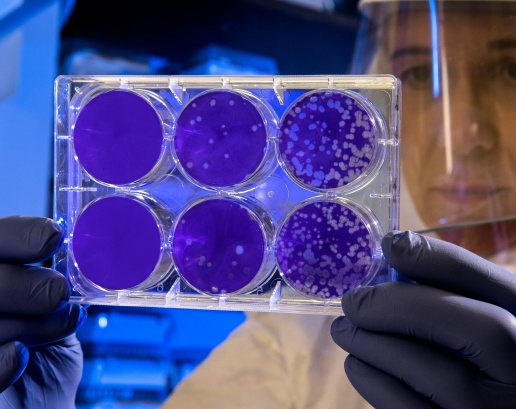

Tecnologie
Per i prossimi tre anni, Fondazione Giacomo Brodolini si occuperà delle attività di ricerca in Italia su disuguaglianze e doppia...
Continua con nuove call l'edizione 2024 di Call4Innovit, il programma di accelerazione per piccole e medie imprese e start up...
Apprendere attraverso stage di lavoro a distanza è possibile, ma a condizione di utilizzare metodi e tecniche di progettazione e...
Continua con una nuova call l'edizione 2024 di Call4Innovit, il programma di accelerazione per piccole e medie imprese e start up...
Prosegue l'edizione 2024 di Call4Innovit, il programma di accelerazione per piccole e medie imprese e start up innovative italiane...
A un anno dall'avvio delle sue attività, Innovit, l'Italian Innovation and Culture Hub a San Francisco gestito da Fondazione...
Con un programma di incontri dedicati a genere, scienza e tecnologia, il Milano Luiss Hub for makers and students gestito da...
La quarta edizione di Call4Innovit, il programma di accelerazione dell' Italian Innovation and Culture Hub a San Francisco...
Su iniziativa del Vicepresidente del Senato Gian Marco Centinaio, martedì 12 settembre 2023 alle ore 15.00 fino alle 16.15 si...